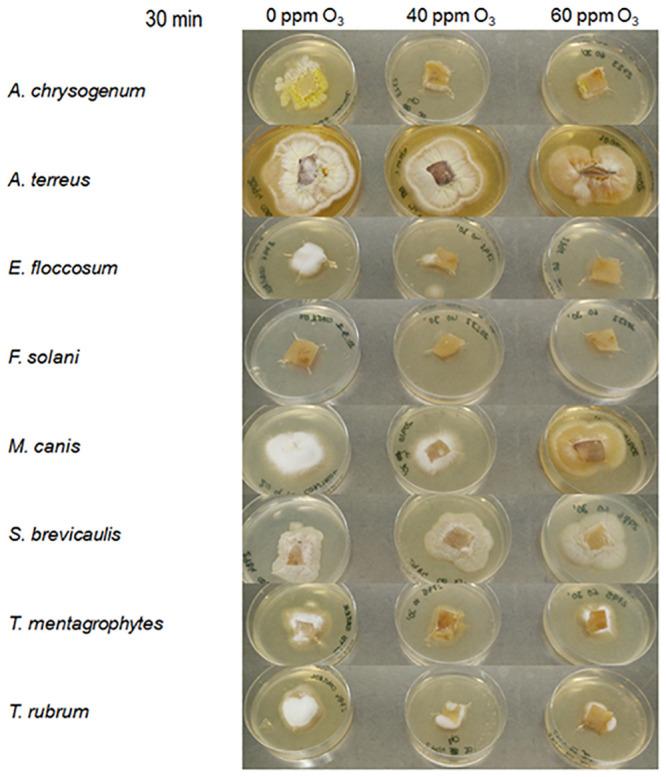
https://cdn.ncbi.nlm.nih.gov/pmc/blobs/81d8/8244860/1a1249aac3cf/pone.0253979.g007.jpg

激光联合臭氧治疗甲真菌病的体外和体内模型。
Combined laser and ozone therapy for onychomycosis in an in vitro and ex vivo model.
机构信息
Departamento de Biología Funcional, Research Unit "Biotechnology in Nutraceuticals and Bioactive Compounds-BIONUC", Área de Microbiología, Universidad de Oviedo, Oviedo, Spain.
Instituto Universitario de Oncología del Principado de Asturias, Oviedo, Spain.
出版信息
PLoS One. 2021 Jun 30;16(6):e0253979. doi: 10.1371/journal.pone.0253979. eCollection 2021.
In order to develop a fast combined method for onychomycosis treatment using an in vitro and an ex vivo models, a combination of two dual-diode lasers at 405 nm and 639 nm wavelengths, in a continuous manner, together with different ozone concentrations (until 80 ppm), was used for performing the experiments on fungal strains growing on PDA agar medium or on pig's hooves samples. In the in vitro model experiments, with 30 min combined treatment, all species are inhibited at 40 ppm ozone concentration, except S. brevicaulis, which didn't show an inhibition in comparison with only ozone treatment. In the ex vivo model experiments, with the same duration and ozone concentration, A. chrysogenum and E. floccosum showed total inhibition; T. mentagrophytes and T. rubrum showed a 75% growth inhibition; M. canis showed a delay in sporulation; and S. brevicaulis and A. terreus did not show growth inhibition. This combined laser and ozone treatment may be developed as a fast therapy for human onychomycosis, as a potential alternative to the use of antifungal drugs with potential side effects and long duration treatments.
为了开发一种使用体外和离体模型治疗甲真菌病的快速联合方法,我们连续使用两种双二极管激光器,波长分别为 405nm 和 639nm,并结合不同的臭氧浓度(最高达 80ppm),对生长在 PDA 琼脂培养基或猪蹄样本上的真菌菌株进行实验。在体外模型实验中,经过 30 分钟的联合处理,除了 S. brevicaulis 之外,所有菌株在 40ppm 臭氧浓度下都受到抑制,而与单独臭氧处理相比,S. brevicaulis 没有显示出抑制作用。在离体模型实验中,在相同的持续时间和臭氧浓度下,A. chrysogenum 和 E. floccosum 显示出完全抑制;T. mentagrophytes 和 T. rubrum 显示出 75%的生长抑制;M. canis 显示出孢子形成延迟;而 S. brevicaulis 和 A. terreus 则没有显示出生长抑制。这种联合激光和臭氧处理可能被开发为治疗人类甲真菌病的快速疗法,作为使用具有潜在副作用和治疗时间长的抗真菌药物的潜在替代方法。